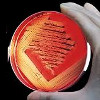

Для уточнения цены и услуги выберите подраздел в начале страницы.
Запись
540-1010₽
+7(915 ..показать +7(499) 11-68-239+7(915) 809-03-03
Столичная Диагностика на Кастанаевской Москва; ул. Кастанаевская, д. 55, корп. 2 ; м. Славянский бульвар
Запись
590-1355₽
+7(861 ..показать +7(499) 11-68-239+7(861) 212-12-81 +7(988) 880-16-52
Семейная Поликлиника в 3-м Звенигородском проезде Краснодар; 3-й Звенигородский пр-д, д. 45 ;
Запись
600-1200₽
+7(383 ..показать +7(499) 11-68-239+7(383) 311-02-11
МЦ Семейный Доктор на Кошурникова Новосибирск; ул. Кошурникова, д. 8 ; м. Березовая роща
Запись
660-2100₽
+7(343 ..показать +7(499) 11-68-239+7(343) 254-66-66 +7(343) 235-15-55 +7(343) 204-73-75
МЦ Гармония на Академика Парина Екатеринбург; ул. Академика Парина, д. 43 ; м. Чкаловская
Запись
700-1320₽
+7(495 ..показать +7(499) 11-68-239+7(495) 127-05-07 +7(925) 127-05-50
СкринДоктор на Павла Андреева Москва; ул. Павла Андреева, д. 4А ; м. Серпуховская
Запись
800-1940₽
+7(495 ..показать +7(499) 11-68-239+7(495) 846-34-89 +7(495) 846-40-53 +7(495) 846-36-03
КБ РЖД-Медицина им. Н.А. Семашко в Киевском Новая Москва; пос. Киевский, д. 12А ; м. Коммунарка
Запись
800-1940₽
+7(499 ..показать +7(499) 11-68-239+7(499) 623-71-92 +7(499) 623-72-06 +7(916) 630-13-93
КБ РЖД-Медицина им. Н.А. Семашко на Плющева Москва; ул. Плющева, д. 15А, стр. 2 ; м. Стахановская
Запись
850-1300₽
+7(343 ..показать +7(499) 11-68-239+7(343) 304-63-03
Детский Доктор на Бакинских Комиссаров Екатеринбург; ул. Бакинских Комиссаров, д. 93 ; м. Проспект Космонавтов
Запись
860-1810₽
+7(499 ..показать +7(499) 11-68-239+7(499) 705-75-25
Клиника доктора Есиповой в Шмитовском проезде Москва; Шмитовский пр-д, д. 16, стр. 2 ; м. Выставочная
Запись
900₽
+7(499 ..показать +7(499) 11-68-239+7(499) 252-59-99
УРО-ПРО на Конюшковской Москва; ул. Конюшковская, д. 26 ; м. Краснопресненская
Запись
990-1320₽
+7(495 ..показать +7(499) 11-68-239+7(495) 988-43-59 +7(495) 978-30-00
Медсервис Диагностика+ Москва; ул. Ленинская Слобода, д. 17 ; м. Автозаводская
Запись
1100-1400₽
+7(495 ..показать +7(499) 11-68-239+7(495) 156-27-12 +7(968) 975-56-69
Карта Здоровья в Лопатино на Солнечном бульваре Московская область; р.п. Лопатино, Солнечный бульвар, д. 9 ; м. Улица Скобелевская
Запись
1200-1955₽
+7(495 ..показать +7(499) 11-68-239+7(495) 363-03-63 +7(800) 200-36-30
ИНВИТРО на Зеленом проспекте Москва; Зеленый пр-т, д. 62, корп. 1 ; м. Новогиреево
Запись
1300-1700₽
+7+7 ( ..показать +7+7 (495) 975-73-39
Атлас на Кременчугской Москва; ул. Кременчугская, д. 3 ; м. Славянский бульвар
Запись
1355₽
+7(499 ..показать +7(499) 11-68-239+7(499) 116-77-93 +7(495) 044-00-03
МЦ ЗдоровыйЯ на Щёлковском шоссе Москва; Щёлковское шоссе, 44, корп. 5 ; м. Щелковская
Запись
1360₽
+7(831 ..показать +7(499) 11-68-239+7(831) 266-71-69
Онли Клиник на проспекте Ленина Нижний Новгород; пр-т Ленина, д. 69, корп. 1 ; м. Пролетарская
Запись
1440-4059₽
+7(843 ..показать +7(499) 11-68-239+7(843) 211-77-60 +7(967) 460-27-09
МЦ Ситидок на Салиха Батыева Казань; ул. Салиха Батыева, д. 1 ; м. Дубравная
Запись
1650₽
+7(383 ..показать +7(499) 11-68-239+7(383) 388-84-72 +7(965) 827-82-69 +7(961) 879-57-27
МЦ Здравица на Красном проспекте Новосибирск; Красный пр-т, д. 323 ; м. Красный проспект
Запись
1800₽
+7(928 ..показать +7(499) 11-68-239+7(928) 120-03-30
Авеню-Стачки на проспекте Стачки Ростов-на-Дону; пр-т Стачки, д. 31 ;
Запись
2100₽
+7(343 ..показать +7(499) 11-68-239+7(343) 254-66-66 +7(343) 204-73-75
МЦ Гармония на Фурманова Екатеринбург; ул. Фурманова, д. 30 ; м. Чкаловская
Ещё клиник - 2498 . Используйте фильтры